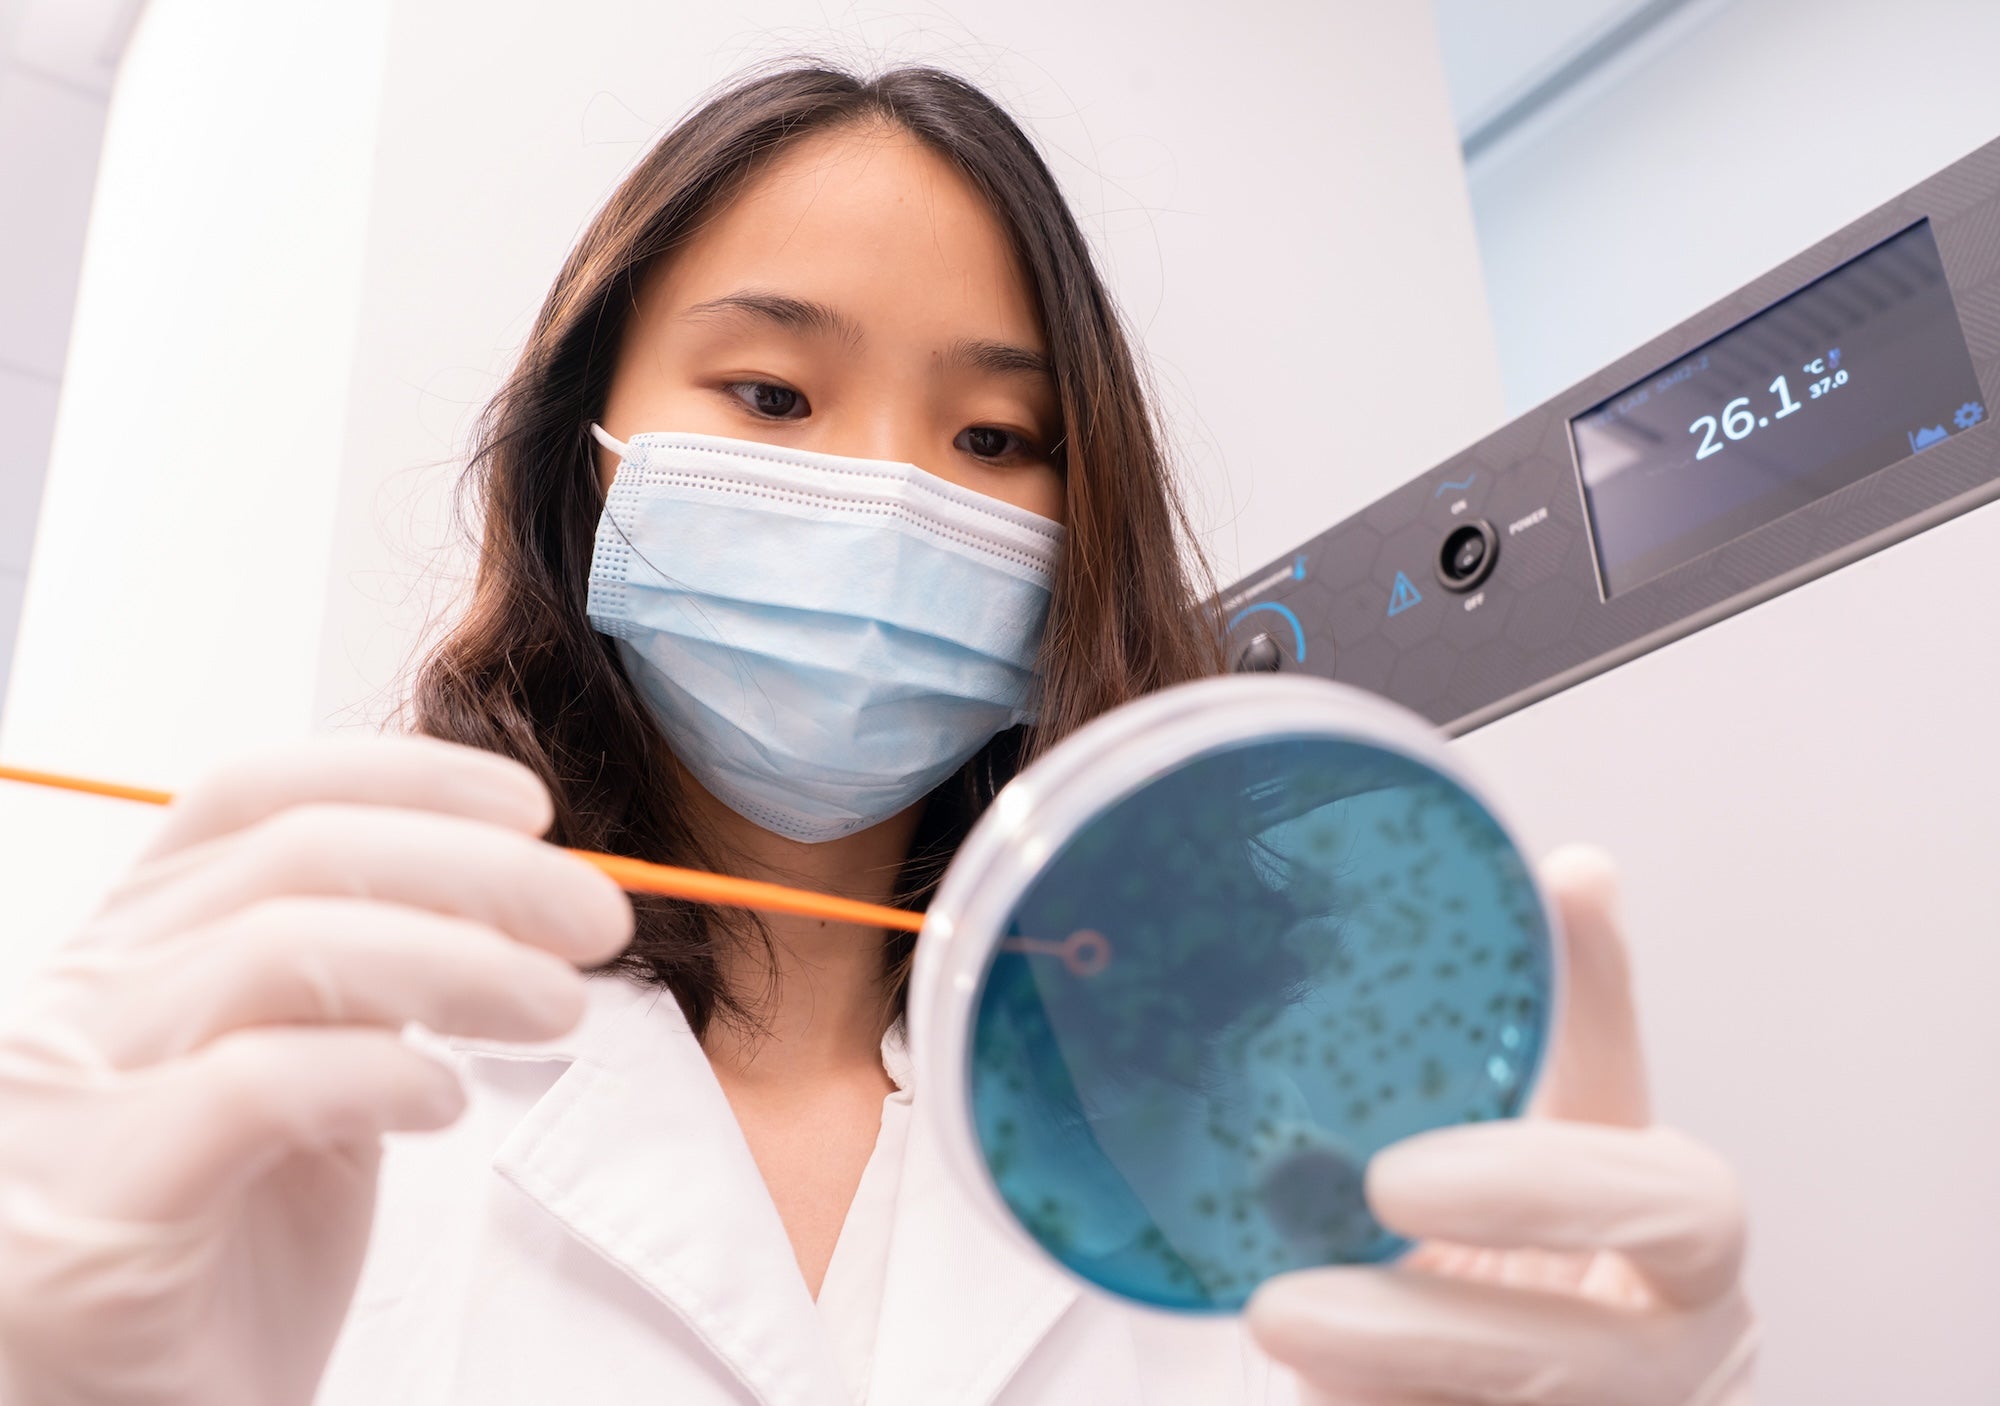

1 The Faculty of Medicine, The Chinese University of Hong Kong.
2 When compared with their unencapsulated probiotic strains. Del Piano M. et al. Evaluation of the intestinal colonization by microencapsulated probiotic bacteria in comparison with the same uncoated strains. J Clin Gastroenterol. 2010 Sep; 44 Suppl 1:S42-6.
3 The Faculty of Medicine of The Chinese University of Hong Kong
4 by G-NiiB internal sales data for our probiotic supplements in Hong Kong
5 Customer survey conducted by G-NiiB GenieBiome Hong Kong in 2022 for customers who previously purchased our gut health products.
6 World Patent No. WO2013114185A1
7 Compared with their non-encapsulated probiotic strains. Del Piano M. et al. Evaluation of the intestinal colonization by microencapsulated probiotic bacteria in comparison with the same uncoated strains. J Clin Gastroenterol. 2010 Sep; 44 Suppl 1:S42-6.
8 Lau, R. I et al. (2023). A synbiotic preparation (SIM01) for post-acute COVID-19 syndrome in Hong Kong (RECOVERY): a randomised, double-blind, placebo-controlled trial. The Lancet. Infectious diseases, S1473-3099(23)00685-0.
9 Wong, M. C. S. et al. (2023). Effects of Gut Microbiome Modulation on Reducing Adverse Health Outcomes among Elderly and Diabetes Patients during the COVID-19 Pandemic: A Randomised, Double-Blind, Placebo-Controlled Trial (IMPACT Study). Nutrients, 15(8), 1982.
10 “40% Of Hong Kong People Show Gut Dysbiosis Comparable to That of COVID-19 Patients CUHK Microbiome Immunity Formula Hastens Recovery of COVID-19 Patients and Offers Hope to Boost Immunity.” The Faculty of Medicine, The Chinese University of Hong Kong, 19 Nov. 2020, https://www.med,cuhk.edu.hk/press-releases/40-of-hong-kong-people-show-gut-dysbiosis-comparable-to-that-of-covid-19-patients-cuhk-microbiome-immunity-formula-hastens-recovery-of-covid-19-patients-and-offers-hope-to-boost-immunity. Press Release.
11 Del Piano M. et al. Evaluation of the intestinal colonization by microencapsulated probiotics supplement bacteria in comparison with the same uncoated strains. J Clin Gastroenterol. 2010 Sep; 44 Suppl 1:S42-6.